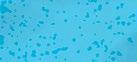

FITTING IN WITH FITTERER’S pg. 12
SKATE OF THE ART
pg. 26
WA MUSIC SPOTLIGHT pg. 36
BEHIND THE COFFIN: THE MAKING OF DRACULA pg. 68


International communication major, Brenda Garcia srikes a pose for the Art of Ballet Folklorico photoshoot (pg.36)

![]()
FITTING IN WITH FITTERER’S pg. 12
SKATE OF THE ART
pg. 26
WA MUSIC SPOTLIGHT pg. 36
BEHIND THE COFFIN: THE MAKING OF DRACULA pg. 68


International communication major, Brenda Garcia srikes a pose for the Art of Ballet Folklorico photoshoot (pg.36)









Fitting in with Fitterer’s pg.12
Fitting with Fitterer’s
Ellensburger Pg.16
Rockin’ Roller
Derby Pg.20
Rockin’ Roller Derby Pg.20
From Whispers to Wagers Pg.24
From to Wagers Pg.24
SKATE OF THE ART pg.26 SKATE THE ART pg.26
Sk8ter Paper Doll pg.35 Sk8ter Paper Doll pg.35
photo by javier angulo design by Zoey Ryan

Pet loneliness, time for a happy pet pg.64 Pet loneliness, time for a happy pg.64
THE TRUTH BETWEEN THE WORDS pg.65 TRUTH BETWEEN THE pg.65 Trinketville pg.66
The art of ballet folklorico pg.36 art of ballet folklorico pg.36
The STORY TELLING OF CORRIDOS pg.46 The OF CORRIDOS
Grunge pg.48 Grunge pg.48
HIPHOP pg.52 pg.52
RAVE pg.54 RAVE pg.54 A Music Locale pg.56 A Music Locale pg.56
YOUR DESTINED MUSIC APP (QUIZ) pg.62 (QUIZ)
Behind the coffin, THE MAKING OF DRACULA pg.66
Behind the coffin, THE MAKING OF DRACULA pg.66 lights, camera, rollie pg.76 camera, rollie
Philip Derise, from NYU to cwu pg.78
Philip Derise, from NYU to cwu pg.78

Creative Director
Zoey Ryan
Lead Designers
Caleb Cleland, Katrina Nolan
Designers
Jade Cupples, Maddie Landon
Social Media Designer Directors
Rieley Iverson
Photographers
Web Manager
Brian Valencia

Find support and accountability
One-on-one, group sessions, and workshops avaliable
Learn strategies for academic and personal success
Tutors meet with small groups
Review class concepts each week
Small group sessions offered for many historically difficult courses
Support at every stage of writing, including graduate work SUBJECT SPECIFIC TUTORING
Offered for all 100 level math courses
One-on-one sessions
Avaliable for Business Administration, Accounting, Biology, Computer Science, Law & Justice, Psychology, and Sociology Courses
Get one-on-one help
Discover different majors and receive academic support
Gain assistance planning courses each quarter
Get help exploring career options online or in-person
509-963-2722 exploratory.advising@cwu.edu




















story by Austin Hardebeck & Charlotte Zombro
photos by Chayton Garcia design by Jade Cupples
Are you bored of your typical shopping locations? If you find yourself thinking yes, then you’re in luck. Recently, an Ellensburg staple reopened with a breath of new life: the Fitterer’s building. With so much love and history put behind it and a central downtown location, maybe your curiosity is piqued. With Fitterer’s back up and ready to do business, PULSE takes a deeper dive into the Fitterer’s building and what can be found housed within.
According to the Yakima Herald, the building was named for the Fitterer brothers who once sold furniture there, the business was handed down from generation to generation until Brad Fitterer’s retirement in 2022. For two years, the building remained dormant and unoccupied until it was purchased by Adam and Kelli Rynd, who sought to bring life back into the historic building and downtown Ellensburg as a whole. “[Fitterer’s] was a great vehicle for us to help give back to the community and certainly contribute to the revitalization and enhanced growth of downtown,” says Adam Rynd. Now, sitting on the corner of Fourth and Main are several businesses and offices all operating out of the three story complex. This led to a landmark reopening for the people of Ellensburg as they couldn’t wait to see what was in store. Or more accurately, stores.




The Rynd family is well in-touch with Ellensburg and have a passion for the downtown aesthetic that the town wears with pride. Because of this, they wanted to be sure that the iconic history of the old furniture store remained, despite its new purpose. “I know that there is a lot of fun things that we found as we were doing the remodel project,” says Kelli Rynd. “We found a really cool old safe that was in there…so there’s history. There was a shootout at one point downtown, where there’s a bullet hole upstairs and one on the second floor. So that was kind of fun, cowboys fighting each other.” This iconic downtown staple is will continue to be revitalized as time goes on thanks to the Rynd’s influence, allowing these new businesses to flourish.
Situated right inside the front door on the ground floor is a barbershop unlike any other in Ellensburg. From custom haircuts, to a variety of men’s clothing to a whiskey bar: Woody’s Classic Man has everything a rugged Ellensburg resident is looking for. Owned by the Rynd’s, this location is the fourth of its kind, and the first to come with a whiskey bar in-house for its customers. Woody’s fills
a niche that Adam Rynd first noticed was unfulfilled years ago. “My wife and I recognized that there were no men’s clothing stores,” says Adam Rynd. “Mills Brothers, which was located in Wenatchee for over 100 years, closed in 2019. So there were no men’s clothing stores in all of Central Washington.” While each shop is stocked with plenty of big name brands, such as Pendleton and 7Diamonds, no two Woody’s Classic Man locations are exactly the same. “Each store has a little different kind of lean,” Adam Rynd says. “In this store it’s a little bit more of a Western lean. In Chelan, it’s a little bit more of a sporty kind of lake lean… our Wenatchee store has a wide variety of things, in addition to a full men’s formal program.” A men’s formal program complete with suit rentals is exactly the kind of personalized shopping experience Adam Rynd intends to have in every Woody’s store. “All of our stores are about experiential retail,” says Adam Rynd. “It’s not just [to] shop, it’s [to] go and experience something.”
Across from the barber chair sits display racks full of handpicked Levi’s and leather jackets with a big name written all over them: Screaming Trees founding drummer, Mark Pickerel. “We also have a special addition with Mark’s
consignment products,” says Adam Rynd. “Mark has become a friend and a vendor in our space here. He’s curated a wonderful collection of vintage clothes.”
With 75 different whiskeys available behind the bar, 30 different cigars for purchase and a barber or two in every location, every Woody’s store is fully stocked for your convenience. “We’re trying to create just a very shoppable men’s experience,” says Adam Rynd. “Men can come in, find what they’re looking for, or maybe what they didn’t necessarily know they were looking for, so they can look good, feel great and smell great.”
A candy and ice cream store that not only fills the need for sugar, but also the need for fun with its wall-to-wall shelves of toys. Just across the way from Woody’s is the Rynd’s second business venture: Ellensburg Sweet Spot. Emily Pease, current store lead and CWU student, speaks on everything that Sweet Spot has to offer. “We make dirty sodas and then a pretty awesome swirl freeze ice cream, which is a soft serve ice cream with a bunch of different toppings you can




add in,” Pease says. “We have a seating area where we have a lot of kids after school… and then our second floor has a lot of games and Legos on it.”
This is a sister location to several of the Rynd’s other stores throughout Washington state and prides itself on being more than a store. Following a similar business model to Woody’s Classic Man, this is a place for “experiential retail.” Pease concludes, “I love seeing everybody come in and get along no matter what. Something off campus like that, as somebody that goes to Central, I really thought it was unique.”
Up the center stairs, on the second floor, is a gift shop and gathering space fittingly named Sparrow’s Nest. The smell of incense leads you past the shopping displays to a meeting area overlooking the foyer of the Fitterer’s building. This is where Greyson and Sparrow Fletcher sell their wares and hold events for the Ellensburg community. Sparrow Fletcher, co-owner and Sparrow’s Nest’s namesake,
puts emphasis on the event aspect of the shop. “What the community was telling us [was that] they wanted a place to gather and do fun things,” says Fletcher. Intending to make Ellensburg a more lively place for everyone, Fletcher keeps her ear to the ground to better meet the needs of the locals. “I really listen when people come in and tell me things,” she says. “I had a mom come in and tell me that her teenagers don’t have anything to do in town and would I consider doing something for teenagers? We had so much fun doing a game night.”
Fletcher recognizes the unique position of having so many different shops in one place, especially in a town like Ellensburg, where Fitterer’s is the only real building of its kind. “It’s a really unique building. It’s being called a mall and we like that,” Fletcher says. “It’s a fun mall where someone can come in and do a whole lot of shopping in one space, which is really great and we needed it.”
If you come to Sparrow’s Nest for an event, you’ll stay for the unique products lining the shelves. “I think the best way to describe us is as an eclectic gift store,”

found a spot perfectly fit for their business. “We were coming back from the farmer’s market on a Saturday and saw the ‘for lease’ signs and we couldn’t believe it,” says Rob Henning. “We saw this last space with the beautiful storefront and the perfect ground floor
desire for year-round local goods, with a focus on food, specifically charcuterie. Rob Henning says, “We’re all about the charcuterie. Helping people put together charcuterie boards, but also helping somebody relax.”
Hennings themselves stand behind for their own home. “The gifts, my wife has impeccable taste,” says Rob Henning. “I have a feeling she keeps bringing things into the store that work best in our home so that I’ll buy them.” The Grazing Table on 4th also offers customizable gift



story by Patrick Pugh & Hope Cox
photos by Chayton Garcia & Keaton Weyers design by Jade Cupples
Since the dawn of time many questions have stumped humanity. Questions that make us question who we are and what our place might be in these vast cosmos we call the universe. PULSE seeks the answer to one such important question, “What is the best burger in all of Ellensburg?” CWU students speak on the various local burger spots and what makes them their favorite and a local eatery weighs in on what makes their burgers special. In addition, a PULSE reporter shares her views on several burgers served around Ellensburg.
One person who’s thrown their hat into the ring is Jace Mears, a junior at CWU and an elementary education major, who claims that the best burger joint in all of Ellensburg is Campus U-Tote-Em. “For me, it’s nostalgic,” says Mears. “My mom went there when she was doing college, she used to eat there. We would stop by whenever we went through Ellensburg.” Another student, Abby Willey, might find it hard to agree with Mears’ assessment. Willey cites the CWU’s
very own Lion’s Rock as her favorite place to acquire the scrumptious meal based on convenience. “I don’t go out... so, it’s just in and out,” says Willey.
As important as it is to get the opinions of ordinary people, it’s just as essential to get the perspective of those who own a burger joint. After all, they’re the ones in the kitchen. Jeremy Custer, co-owner of The Ridge (a restaurant and bar located in Ellensburg) explains not only what makes a great burger, but also what makes a great burger experience. First, he brings up the fact they serve
two different types of sandwiches at different times to help fit customers’ moods. “We’ve got the Smash Burger and the Ribeye Burger. Smash Burger, we wanted something that we could do fairly quick [and] easy. I mean honestly, they’re straight forward burgers but if you do them right, they’re amazing,” says Custer. “The other burger [is] the Ribeye Burger and we use the ribeye trimmings and fat that get cut in with all the beef. It just gives it an extra amount of richness, which people love.”
Custer also explains what makes going to a burger joint so special, specifically at his place, “You have service everywhere. What sets it apart is the focus on hospitality... The idea is making them feel special so that they want to come back. They want to tell other people how great everyone treated them as they came in. That really carries a lot of weight in this town. I think it carries a lot of weight anywhere, but this town specifically.”
PULSE reporter, Hope Cox, visited several local eateries and now gives her opinion on what the best places are for readers to try out on their own.
The Wildcat Burger consists of bacon, cheese, an onion ring and BBQ sauce. The burger came wrapped in a napkin to keep your hands from getting too messy. It was well-constructed and not squished, unlike what you would experience from a fast food chain like McDonald’s. The burger had a good crunch between the onion ring and crispy bacon. The cheese melted perfectly around the beef patty and there was a good sauce-to-burger ratio. The BBQ sauce added sweetness and tanginess which paired well with the savory beef patty and salty bacon. This was a great burger.
The Campus Burger is a deluxe burger that consists of bacon and cheese. It was well-constructed and easy to see all the different layers. The bacon, onions and pickles had a satisfying crunch. The sauce dripped a little with each bite. A solid choice.



All burgers from The Tav include mayo, lettuce, tomato, relish and pickles on a toasted sesame seed bun.
The Super Mother is a quarter-pounder with American cheese and ham or bacon. The burger was well constructed. The bacon was crispy and savory. The beef patty was a little bland and had a noticeable charred taste. The pickles were tangy and crunchy and the relish was sweet. The mayo was mostly in the middle and not spread evenly throughout the bun. The edges of the burger were a little dry. The first bite was bland but got a little better with each bite. Overall, Mediocre.
On the other hand, the Super Garlic Mother is a quarter-pounder topped with fresh garlic and cheddar cheese. The beef patty was bland beside the charred taste from the grill. The burger lacked the taste of garlic. Not as good as advertised. Neither burger was completely finished and only a few bites were taken because of the bland taste.




The Palace Cafe is a local restaurant located on Main St. All burgers include crisp iceberg lettuce, tomato, pickle, sweet onion, mustard-laced relish and mayonnaise on a freshly baked sesame bun.
The Bacon Cheeseburger consists of crispy bacon strips and Tillamook cheddar cheese. However, the burger lacked structural integrity, and had fallen into two piles on the plate before reaching the table. The top half consisted of a fistful of shredded lettuce, tangy pickles and rings of white onion. The bottom half consisted of the well-seasoned juicy beef patty topped with melted cheddar cheese wrapped around the patty, and strips of crispy bacon strips. Once assembled, it became a tall burger and a mouthful to eat. Each bite, a new adventure of sweet, savory and tangy flavors bouncing from taste bud to taste bud. Overall, a great burger, with subpar presentation.

The Caprese Burger is a grilled herb-infused turkey patty on a ciabatta bun with basil aioli, fresh mozzarella, roma tomato and fresh basil. Served on a plate, sliced down the middle. The basil had a very prominent flavor and paired well with the juicy, savory patty. The tomatoes were not evenly spread throughout the burger. The burger tasted similar to a margarita pizza, so if that is your go-to choice of pizza, then this is the burger for you.













story by Gilberto Martinez-Camacho design by Katrina Nolan
Think your March Madness bracket is killer? Now you can actually cash in on those predictions. Legalized sports betting is sweeping the nation, with billions of dollars being wagered every year. The practice of sports betting is going mainstream, with apps, websites and in-person locations popping up all over. However, with this easy access comes a need for responsible gambling and understanding the potential risks.
What is the sports betting scene in the U.S. like? It’s practically mainstream thanks to a 2018 Supreme Court decision that gave states the green light to legalize sports wagering. Thirtyeight states and Washington D.C. have jumped on the bandwagon, creating a massive industry that raked in over $100 billion in wagers, plus nearly $2 billion in tax revenue for state and local governments according to taxfoundation. org. This rapid growth has a flip side. There’s a rising concern about problem gambling, especially among young people. With online platforms so easy to access and marketing campaigns in overdrive, it’s easier than ever to get in over your head.
Sean Green, the voice behind “The Sports Gambling Podcast,” has answers as to the impacts of legalized betting on sports. What exactly is sports betting? Green breaks it down simply, stating
that it’s “wagering money on a specific outcome.” That outcome could be anything from who wins the Super Bowl to whether the next pitch is a ball or a strike. Green emphasized the sheer variety of bets you can make. It’s a whole world of possibilities, from predicting final scores and point spreads to guessing which player will score the first touchdown.
Unlike many other states where you can place a bet online or at a casino, Washington state decided to keep sports betting within tribal casinos only. Kelly Main from the WSGC (Washington State Gambling Commission) explains that this is rooted in “Washington’s history with gambling and its conservative approach to regulation.” They’re taking a cautious approach, trying to find that sweet spot between economic benefits and potential social costs. Another Washington quirk is that it’s illegal to bet on local college teams. Troy Kirby, also from the WSGC, explains this rule came about through collaboration between the Gambling Commission and the tribes. It’s all about protecting the integrity of college sports and preventing any conflicts of interest. Some might see it as a bummer, but it shows how seriously Washington takes responsible gambling.
While sports betting can be fun, it’s crucial to remember it is still gambling and that comes with risks. Addiction is a serious concern. The excitement of winning can be a powerful pull and it’s easy to get caught up chasing losses or betting more than you can afford. Sean Green is upfront about this, saying, “There is a percentage of the population that has addiction issues.”
And with online platforms making it so convenient, it’s even easier to fall into unhealthy habits.
The good news is that according to Main and Kirby, the WSGC is on top of this. They offer resources for people struggling with gambling addiction and have even set up self-exclusion programs, where you can basically ban yourself from gambling, either for a while or permanently. It’s a proactive way to help people stay in control.
Green had some wise words about recognizing the signs of a problem. He said to ask yourself if gambling is “impacting your life in a bigger sense,” such as affecting your finances, relationships or overall well-being. He
put it this way: “If it’s impacting your life or just impacting your life outside of just ‘oh, hey this is a hundred dollars,’ like win or lose it either way, doesn’t ruin my day. Ruin my life. Hey, if I win, that’s fun.” Basically, if it stops being just a bit of fun and starts to take over, it’s time to take a step back. Remember, there are no guarantees in gambling. Even the experts have losing streaks. The key is to be responsible, set limits and never bet more than you can afford to lose.
Green’s advice for college students? Keep it fun and responsible. Don’t get sucked in by those “free bet” offers or think you’ll get rich quick. Treat it like entertainment and only bet what you can afford to lose, such as the money you’d spend on a night out with friends. Lastly
There are countless ways to place your bets. Here’s a quick rundown:
The simplest form, you’re just picking the winner.
Feeling bold? Combine multiple bets for a potentially huge payout. But remember, higher risk, higher reward. If one leg of your parlay fails, you lose the whole thing.
This is where things get strategic. The sportsbook gives one team a point advantage to even the odds, making it interesting to bet on the underdog.
Forget who wins; this bet is all about the total points scored in a game. Will it be over or under the number set by the sportsbook?
These are the fun ones. Want to bet on who scores the first touchdown, how many three-pointers a player makes, or even what color Gatorade gets dumped on the winning coach? Prop bets are where it’s at.
and most importantly, if you feel like it’s becoming a problem, don’t hesitate to reach out for help.

(photo essay)















































































































































































































































































































































































































































































































































































































































































































































































































































































story by Larissa Baldovinos

The stage glows in a warm golden hue as a chorus of violins and trumpets fills the theater. Dancers, adorned in brightly colored skirts and charro suits, move in perfect unison. Their feet strike the floor in rhythmic bursts that echo like a heartbeat. You watch wide-eyed in wonder, captivated by the vibrant whirlwind of color and sound. Ballet Folklórico is more than just a performance. It is a celebration of history, identity and resilience. Across Mexico and beyond, this traditional dance form continues to captivate audiences, passing down stories through intricate footwork and elaborate costumes. PULSE delves into the roots of Ballet Folklórico, its regional variations and the passion of those who keep it alive today.


Ballet folklórico, a vibrant fusion of classical ballet and traditional folk dance, offers a modern reimagining of Mexico’s deep-rooted cultural heritage. This art form embodies the ongoing interplay of indigenous, African and European influences that have shaped the nation’s identity. Its origins can be traced to Mexico’s indigenous communities where regions like Veracruz, Oaxaca and Yucatán developed dances and rituals reflecting their connection to nature, spirituality and the cosmos. More than just a means of expression, these dances also served as acts of resistance, particularly during
Brenda Garcia, a sophomore international communications major and co-leader of CWU’s folklórico team, highlights this history when discussing dances from Veracruz. “While it is a wedding traditional dance, originally the folk song ‘La Bamba’ was sung by African slaves who escaped Spanish colonialists and hid in the mountains of Veracruz with the help of indigenous people from many places inside Veracruz,” she shares. This example reflects the enduring spirit of survival and cultural blending within folklórico, emphasizing the interplay of different cultures and identities.
Adrian Olivas, executive director of Bailadores de Bronce in Seattle, explains how ballet folklórico evolved through a combination of cultural influences. “There are European styles, native styles, even with pre-Hispanic elements and then Aztec and Mayan cultures, which evolve, especially after the Spanish came,” he says. Olivas also highlights the deep regional diversity in Mexican dance styles, noting how specific cultural exchanges shaped them. “In Guerrero, you see Chilenos influenced by Chilean ships that stopped there during the gold rush in


with green eyes. In Durango, you have German and Austrian influences. That’s why you see the polkas.”
Polkas, which originated in Bohemia and spread across Europe before reaching the Americas, became a key part of Mexican folk traditions, especially in regions like Durango. There the blend of European and Mexican influences is reflected in local dance styles, often performed with brass bands or accordion music.
Ballet folklórico is more than a performance; it is a vivid embodiment of Mexican identity. Every twirl, every step and every beat carries the weight of history and the stories of those who came before. Offering a snapshot of its diverse regions, struggles and triumphs. As a living expression of pride and resilience, it connects dancers and audiences alike to a shared cultural heritage. The blending of different cultural elements is central to the form’s significance. Take the Son Jarocho from Veracruz for instance, a fusion of indigenous rhythms, African percussion and Spanish melodies. This dance speaks to the larger story of mestizaje, the blending





“The power of the native dance, the power of these influences that have come into our days, this is what makes the folklore so rich. Not just steps, it has a meaning.”
Amalia Hernández, Mexican choreographer, founder of Ballet Folklórico de México
Ballet folklórico is as much about storytelling as it is movement. Each dance embodies a distinct narrative, using rhythm, music and choreography to portray the history and culture of Mexico’s diverse regions. Through these dances, performers share the stories of their ancestors—stories of celebration, mourning, resistance and hope.
One of the most iconic dances is “Jarabe Tapatío” (Mexican Hat Dance). Originating from Jalisco, it depicts a flirtatious courtship between a man and a woman. Christina Olivas, artistic director of Bailadores de Bronce, describes it as “...A partnership dance. Either the guy chasing the girl or the girl chasing the guy. It’s usually a love story.” The male dancer often moves with a “stoic” demeanor, while the female dancer moves with grace and energy, symbolizing courtship.
Alexa Silva, a junior forensic economics major and co-leader of CWU’s folklórico group, shares that Sinaloa is her favorite region, describing it as “very carnival themed and really fun,” which evokes the lively spirit of the Carnaval de Mazatlán, one of the largest carnivals in the world, behind only Rio de Janeiro and New Orleans.
Also related to Sinaloa is the “Danza de Venado”

(Dance of the Deer), a powerful and ancient dance rooted in the Yaqui people of northern Mexico.
Building on vibrant energy, the “Danza de los Viejitos” (Dance of the Old Men) from Michoacán showcases older men who express both humor and wisdom through their movements. Dressed in elderly costumes with exaggerated masks, they perform playful, energetic steps. The dance symbolizes the cycle of life, the role of elders in society and the respect they command. In some cases, prominent community men are honored by performing this dance. Garcia describes the style of Guerrero, saying it involves “hip movement and flat feet, sometimes performed barefoot.” These grounded, deliberate movements help
dancers spiritually connect to the earth and their cultural roots. Before enjoying the movements of a dance, one must first take in the trajes (costumes), which play a crucial role, serving as vibrant symbolism. As Adrian Olivas explains, they are “a visual representation of the traditions in each region,” embodying indigenous roots and historical influences. For example, in Aguascalientes, traditional outfits feature vibrant dresses adorned with lace and ribbons, reflecting the state’s agricultural heritage. In Chihuahua, costumes highlight rural and ranching traditions, while Hidalgo’s attire is marked by intricate embroidery that connects to the Otomi culture. Yucatán’s light huipils (loosefitting tunics) tie the attire to Mayan heritage, symbolizing the region’s cultural legacy.
In Guerrero, Garcia shares that the women’s attire features bright yellow baloné skirts, which represent “...The flowers of quadril,” referring to the region’s traditional flora. She gave some insight on Veracruz, where the costumes are a reflection of how the state has evolved, noting that “Flowers in the hair symbolize a new beginning,” which ties back to the region’s colonial past. Adrian Olivas further emphasizes that the costumes from each region are “a connection to their roots and a symbol of the sacrifices made by their ancestors.” In the contemporary era, ballet folklórico is evolving, with modern performers incorporating elements of hip-hop, jazz and contemporary dance. This adaptation helps engage younger generations, especially at Quinceañera parties where it is custom to perform dances to your family and friends. Christina Olivas discusses the balance between honoring tradition and embracing innovation, noting that choreographers face the challenge of keeping folklórico fresh while respecting its lineage. “Once it’s on stage, it’s no longer considered tradition anymore,” she says, “or once you put in a certain move or you’ve done this and that… that makes it less traditional.”
In the United States, especially in areas with large MexicanAmerican populations, ballet folklórico serves as a vital link to cultural heritage. As Silva expresses, “No matter where you come from or where you are now, you can always reconnect with your culture, especially when it comes to dancing.” This resonates deeply with many immigrants and their children, who struggle to preserve their cultural identity while adapting to mainstream society.
Ballet folklórico becomes an act of resistance, allowing individuals to celebrate their heritage openly and reject pressures to conform. It also acts as a bridge to their roots, staying connected to traditions while engaging with new environments, and raising awareness about the Mexican-American experience through community celebrations and educational programs.
As a cultural artifact and artistic expression, ballet folklórico is especially significant in a society where cultural assimilation has long been encouraged. Marginalized communities, particularly Indigenous populations have faced efforts to erase their cultural identities. In an interview with the Los Angeles Times, Mexican choreographer and founder of Ballet Folklórico de México Amalia Hernández shares, “The power of the native
dance, the power of these influences that have come into our days, this is what makes the folklore so rich. Not just steps, it has a meaning.” Folklórico stands in defiance of cultural erasure, ensuring these communities retain space to tell their stories and celebrate their roots. With each generation, certain stories may be lost, swallowed up by time or diminished through the lens of modernity. What elements of folklore history have already been altered or erased—whether deliberately or unintentionally—and how can they be preserved before they fade completely?

Brenda Garcia and Alexa Silva have been friends since early elementary school. Garcia’s curiosity about her culture sparked an interest in mariachi during middle school, leading her to seek new opportunities. She turned to Silva, a lifelong dancer, who encouraged her to join their local folklórico group in high school. Their shared passion for dance and Mexican artistry continued into college at CWU. After a few years of getting involved on campus, they decided to expand that passion within the Latinx Student Organization (LSO). In Fall 2024, they launched CWU’s Folklórico Group, offering Latino students a space to connect with their heritage—one zapateado and twirl at a time.











Brian Valencia Jade Cupples
Music throughout history evolves with the society it’s born into; corridos aren’t any different. Rooted in storytelling, music once sung within the empty borderlands of the Southwest now dominates charts, taking artists to places they couldn’t dream of—Grammys and interviews on late-night TV. From telling stories of heroes and outlaws to electric sounds, this genre has captivated audiences young and old.
With the rise of organized crime, drug use and the disconnect between generations, why does music matter? Why does the unique storytelling angle of corridos matter in social commentary?
Corridos have origins in the early to mid-19th century in the old Southwest. Old folk music about heroes, outlaws and battles helped it gain regional popularity—but it was also practical for people to hear what was happening. “At the beginning, it was a form of newspaper in some ways because it was popular with a lot of people… it was a way to understand what was going on in


the country,” says Miguel Cabañas, an associate professor of Latin American and Chicano/Latin studies at Michigan State University. Its popularity rose during the Mexican Revolution, creating a new art form. “It would narrate the culture of our people. Before, corridos were stories,” says Juan Villagran, vocalist and radio host for Radio Mexicana 99.7 FM. “You’d hear one, and it felt like watching a movie.”
Corridos became ingrained in Mexican culture. Its popularity was solidified during the golden age of Mexican films—movies that showcased songs like “Corrido de Jorge Torres” and “La Feria de las Flores”.
The sound of corridos has remained relatively similar to when it started. Dominico Cañon, an artist and composer for Lado Exclusivo, says there are a few standout subgenres of corridos that are instrumentally different but share similar sounds. “Banda corridos use brass instruments, trumpets, clarinets, charchetas and are more dynamic as opposed to other corridos,” says Cañon. “Norteños are played with accordion, drums, tuba, bass, and bajo sexto. Sier-
reño corridos are played with a guitar as harmony, requinto, bass, tuba or tololoche, and charchetas.”
Corridos tackling themes of drug trafficking, known as narcocorridos or corridos bélicos, eventually began to emerge. “Smuggling was common all throughout the 20th century—cigarettes, drugs, alcohol. Especially when there was prohibition in the U.S., illegal substances would go back and forth,” says Cabañas. But its chokehold on mainstream music wasn’t solidified until the following decades. It wasn’t until the ’70s and ’80s that artists changed what singing and composing a corrido meant.
For younger generations, narcocorridos were a seamless transition. “Young Mexicans started to sing rap and things like that, but something was missing. It was the identity that was missing,” says Cabañas. “They went to gangster rap. It was on the rise, and the topics of violence, drugs and the police state were part of that era.”
Because of the Mexican music industry’s success, it became an easy target for early Sinaloa cartels, which originated in



the Golden Triangle region of western Mexico—the heart of the Mexican drug trade. “Many of the original creators of narcocorridos came from Mexico’s gulf state of Sinaloa,” says Parker Asmann, a journalist at InSight Crime. “Drug trafficking groups in general have long paid musicians to write songs about their activities.”
While some artists were and continue to be paid to sing and narrate cartel stories, the narcocorridos subgenre was already rising. It was a way to connect with the struggles of the time—an ugly reality that continues throughout the ongoing drug war.
listeners, transcending its popularity globally. Grammy-winning artists like Peso Pluma are pioneers of corridos tumbados, a genre that mixes regional Mexican music with trap, often emphasizing marijuana use, similar to rap. “With the instruments selected in tumbados, you see more guitars and electric bass, bajoloche (acoustic guitar), and acoustic bass with a slapping sound,” says Cañon.

Since prohibition in the early 20th century and even the ’70s and ’80s, the cartel and migration landscape has changed significantly. Dozens of groups currently control different criminal economies and different territories. “The organized crime landscape is more complex and fragmented than the landscape we had 20 or 30 years ago,” says Asmann.
The infamous drug war continues in major U.S. cities with increased drug abuse, as well as states throughout Mexico reaching a record number of homicides. It’s becoming difficult to ignore.
There’s been a push to ban corridos that discuss drug-related violence, like narcocorridos, corridos bélicos and tumbados, but with limited success. Mexico and the U.S. have continued to collaborate to stop the flow of drugs and violence. “Homicide in Mexico has reached historic levels ever since the Mexican government, with the support of the United States, initiated the militarized crackdown in 2006,” says Asmann.
Thanks to the genre’s massive popularity in Latin America, it has spawned a subgenre that resonates with younger

Music reflects stories and topics relatable to the youth. For Cabañas, corridos, like many other genres, mirror the system they exist within. “Young people want to become part of the core of capitalism. They want power, they want visibility—people seeing them in their car,” he explains. Flashy cars and designer clothes give people status. Cabañas sees consumption as a way for young people to claim status.
While older generations understand that music is usually a fantasy, there’s a reason they aren’t fond of the changes. “Nowadays, the youth sing corridos and don’t know what they’re singing—they simply just do it. It used to be stories of real life and real events and those were the original corridos,” Villagran says. He understands the money behind the business and hopes the youth don’t fall into vices, as he’s seen it numerous times. “I’ve worked with lots of artists and heard their stories … lots of artists have fallen into [drug addiction] and passed away or gone to prison,” says Villagran. “There’s lots of people in power who don’t want our youth to make it because it’s going to affect them when they develop those intelligences.”
While the border and drug crisis continues, corridos reflect grander social issues, evolving as the culture finds its connection to its tradition. Corridos are one of many popular genres in Latin America and they’ll continue evolving as there are more stories to tell.




Why conform? The sound and attitude of grunge solidified Washington as one of the most important cities in the history of rock music. Its originality and “anyone can do it” attitude reshaped American pop culture and music.
Grunge brought the counter-cultural attitude of punk to the front of the mainstream. Many critics of the time highlighted how grunge succeeded as a musical style that was beloved because it was unique and emotionally powerful, not technically impressive or radio ready.
“Nobody sounds like that at all,” says Rudy Gerdeman, a WWCD radio host whose career spans back to the ‘90s. “No other scene in LA, New York, Chicago, Cincinnati, anywhere. Seattle had its own thing that nobody’s replicated since the early 90s.”
The Seattle alternative scene took the raw energy of hardcore punk, the heavy and distorted guitar sounds of sludge metal and the bizarre and creative nature of the indie scene and blended it all together. Multiple Seattle bands gained an underground following throughout the ‘80s, with members from one popular band often leaving and going on to join or form another. After Nirvana released Nevermind and changed music, many of these bands went on to perform together in arenas across the world. The importance of the unity within the Seattle scene cannot be understated. “There was a vacuum for original music because the industry wasn’t promoting it
so people just put it out themselves,” said Jason Benjamin Clifton, lead vocalist of local band SixGun. “Indie music, faith no more, that’s what spawned Nirvana. Punk had taken it as far as it could. Punk alone wasn’t gonna be a thing, it had to become what it came to keep going. The caterpillar must become the butterfly.”
Originality is something that mainstream rock had become deprived of by the late ‘80s. Hair metal bands sounded too alike and had catalogs full of music that was focused on radio success and not enough on creativity. Alternative music got its name because it was an alternative to the sound that was being promoted in the mainstream, much like Indie got its name because its artists were signed to independent labels. While not from Washington, Pixies are a legendary and heavily influential band that tied together and pioneered the sound of both of these scenes. In a Rolling Stone interview in 1994, Kurt Cobain spoke on their influence. “When I heard the Pixies for the first time, I connected with that band so heavily, I should have been in that band - or at least in a Pixies cover band,” Cobain said.
a band like Nirvana where the band essentially looked like everyone and their friends at high school and it was proof that anyone can do it.”
Grunge began before the tech booms of Amazon and Microsoft. At the time, Washington was not an economic superpower and expensive housing wasn’t a defining feature of Seattle. Working class Washingtonians wore flannels and Doc Martens because they often had to work in cold conditions to survive. They needed clothes that were affordable and warm, ones that they could wear on days of cloudy skies and pouring rain.


Before Nevermind, mainstream success was separate from average society, with the idea of a “rockstar” being something that was somewhat superficial and unattainable to the average person. It seemed like only the most skilled and charismatic people could become rockstars and musicians that wanted to make it big had to promote themselves in accordance with an image of what the mainstream defined as successful. The lifestyle that hair metal was promoting excluded most people. Chris Cornell, frontman of legendary Seattle band Soundgarden, talked about how Nirvana changed music in a 1994 interview with Kiro 7 News. “You went from seeing a video of a band like White Snake where you have the singer’s model wife doing a striptease act on the hood of a Jaguar and basically all of these rock bands presenting themselves as having a lifestyle that you will never have, that’s very special and it’s very exclusive,” Cornell said. “Then you see a video with
Screaming Trees were a legendary grunge band founded in Ellensburg. Mark Pickerel, Screaming Trees founding drummer and creator of local clothing brand Road Trip Records, talks grunge fashion. “We liked this idea of wearing clothes that were synonymous with blue collar work, with migrant workers, identifying with people who worked in the logging industry, the agriculture… It was also attractive to us because it was affordable. We were living in Ellensburg where we didn’t really have a lot of options when it came to finding clothes to wear on stage,” Pickerel says, “It was convenient for us that flannels and denim and work boots and suspenders had become the dress code for grunge bands. It eliminated this pressure to spend money on clothes that we couldn’t afford or find.”
Coming from punk, protest against oppression and inequality was an integral part of grunge culture. The glamorous aspect of ‘80s hair metal had grown stale by the end of the decade and people became sick of the over-sexualized nature of the genre. Anti-sexist lyrical content was part of the foundations of grunge and remained present throughout, with songs like Soundgarden’s “Big Dumb Sex” helping define the early grunge Scene and “Polly” by Nirvana becoming a fan favorite.
On the liner notes of “Incesticide,” Kurt Cobain wrote “If any of you in any way hate homosexuals, people of color, or women, please do this one favor for usleave us the f–k alone.”
Nirvana incorporated lyrics related to the topic throughout their catalog, describing “Rape Me” as having been written with the intention of making his lyrics blatantly apparent. “I got tired of people trying to put too much meaning into my lyrics, so I decided to be really blunt and bold,” said Cobain. After a decade of music that made it seem like only a specific type of person could be successful through looking a certain way, grunge came along, shattered this notion and said that anyone could do it through being themselves.
Founded in Ellensburg, Screaming Trees carved out a unique place as pioneers in the alternative scene, drawing more from psychedelic and southern rock than their metal and punk influenced Seattle counterparts. Mark Lanegan, the bands lead singer, is considered one of the greatest baritone singers in rock history, with a sorrowful, beautifully smooth and powerful tone as well as brilliant poetic lyrics. The band’s 1992 album” Sweet Oblivion” stood out in the mainstream as it was still distinctly grunge, but much more melancholy in comparison to its somber Seattle counterparts.
Today, Screaming Trees and Mark Lanegan stand out even more. In the ‘90s, grunge perfectly captured the vibe of Seattle - music that was raw and energetic but somber at the same time matched a city with pouring rain, cloudy skies and a vibrant urban underground. While these terms still define Washington, listening to Pearl Jam or Alice in Chains doesn’t bring to mind blocks of expensive company buildings or the Amazon Headquarters. Eastern Washington, however, is still rolling hills, clear skies and farm country. “Sweet Oblivion” and the rest of the Screaming Trees catalog captures this vibe nearly perfectly. Jason Benjamin Clifton described Lanegan’s importance. “When Lanegan came in he just dropped the hammer with the lyrics and the voice, he was their Johnny Cash.” Clifton painted a Screaming Trees mural that can be found posted against a wall in an alleyway near D&M Coffee on Pearl Street.
Pickerel gave a unique story of how the success of Screaming Trees was tied to CWU.
“I give a lot of credit to CWU for energizing and helping propel the band into an international marketplace,” says Pickerel. While there was much unity in the alternative scene at the time, Pickerel has a perspective on the competitive side. “Our first record that we put out ourselves, called ‘Clairvoyance’ got a horrible review in The Observer, so our first public acknowledgement from CWU was a really negative one in the form of an awful review written by someone that worked for The Observer that was also in a competing band,” Pickerel says. “At first our impression was that we were gonna have a hard time winning the fans and support from kids on campus.”
Success really started brewing for Screaming Trees when they got signed to SST in 1987. “When we got signed to that label, that really boosted our reputation, it put us on the map internationally. That’s when we started to enjoy some success outside of Ellensburg,” says Pickerel. “Prior to that we didn’t really have a local following, we weren’t asked to play at any of the local bars. Our music was too edgy and subversive to appeal to the 21 and over crowd at the time.”
CWU’s campus was instrumental to the band’s early success. Screaming Trees advertised by putting flyers around campus and playing shows at Hal Holmes Community Center downtown. The ‘Burg radio station, at the time called KCAT, were impressed by the work Screaming Trees did with SST, appreciating and promoting the band’s music more once they got word of the accomplishment. Screaming Trees worked with many CWU graduates and students during their early years. Steve Fisk, the band’s first producer, spent time in CWU’s music department. Another graduate owned a local studio that the band recorded in and Mark Lanegan’s girlfriend at the time helped the band design album covers and set up photo shoots with people in the photography department.


“We were really lucky because we had access to Central’s art department where people could literally do work on our behalf and get credits for it,” Pickerel says. “They could use it to beef up their own program on campus, beef up their own credentials or grades. That was really convenient to us, I don’t think it was lost on us that we were lucky to have that baked into being an Ellensburg band. The more I look back on our early development of the band, the more I recognize how much the support from CWU and the community throughout Kittitas Valley, [and] what an integral role that played in our development and confidence and self-esteem.
story by Ja’ Kai Thomas design by Maddie Landon
In a city that is renowned for its alternative rock, Seattle’s hip-hop roots have stayed in the background, largely forgotten by the rest of the world. With so much involvement in the hip-hop space, you have to wonder why so little of its history is talked about. Seattle hiphop reflects both the underground and above ground music space. Many artists in the Seattle area have and continue to dip their toes into the industry. You just need to know where to look.
Amidst the tech-driven innovations and coffee culture that define Seattle, a vibrant hip-hop scene has grown, nurtured by passionate artists and fans alike. The city, often celebrated for its grunge and alternative rock, harbors an equally compelling history of hip-hop evolution, shaped by talented DJs, rappers and producers who left their imprint on the culture.
Hip-hop found its way into Seattle’s local consciousness largely due to the efforts of DJ Des “Nasty’’ Rodriguez.


As noted in a 2023 NPR article by Daudi Abe, Rodriguez, originally from the Philippines, introduced Seattle to live-mixing and scratching through his signature “Mastermixes”— 30-minute DJ sets broadcast on the radio. His energetic style and groundbreaking approach ignited interest in hip-hop throughout the city, offering audiences a new sound that resonated with the community.
Rodriguez soon became a regular at the Boys & Girls Club’s weekly parties in Seattle’s historically Black Central District. These gatherings were more than just events; they became cultural hubs where hip-hop enthusiasts came together to celebrate the genre, sharing ideas, talents and ambitions. It was at one of these parties that Rodriguez crossed paths with the party’s host, a rising artist named Sir Mix-a-Lot. Their meeting would mark the beginning of a collaboration that helped propel the Seattle scene forever.
Together with Ed Lock and Greg Jones, Rodriguez and Sir Mix-a-Lot co-founded Nastymix Records in 1985. According to the NPR interview with Abe, this independent label operated with a modest team of just ten people, yet its impact was anything but small. Despite its limited resources, Nastymix became a force to be reckoned with. Within two years, the label released two Sir Mixa-Lot albums — certified by the Recording Industry Association of America (RIAA). This remarkable success put Seattle’s hip-hop scene on the map and inspired many aspiring artists to believe in the possibility of making it big.
Nastymix Records would reach its end
in 1992, only a year after Sir Mix-aLot departed from the label, taking his fans along with him. The label’s seven year run left a big mark on the hip-hop industry. It became the blueprint for a label that puts out local music and reaches a global audience simultaneously, a blueprint that several entrepreneurs in the hip-hop industry would closely imitate. Nastymix proved that even a small label from a city not typically associated with hip-hop could make waves on a national level, influencing independent labels that followed in its footsteps.
The Foundation laid by Sir Mix-a-Lot and Rodriguez paved the way for a fresh generation of Seattle hip-hop artists to emerge in the 1990s. The Scene flourished, with a mix of newcomers and seasoned talents collaborating to push the genre forward. Among them was Ghetto Children, a group formed by “Vitamin D” Brown and William “B-Self” Rider while they were still students at Garfield High School. According to Abe, their passion for music eventually led them to create their own production companies, Tribal Music Inc. and Tribal Productions, setting a standard for the next wave of producers and artists in the city.
Brown, in particular, remains an influential figure in Seattle’s hip-hop scene.“Through it all, the scene was held down by Vitamin D, creator of legendary Central District basement recording studio The Pharmacy, and son of Motown legend and Ozone member Herman Brown,” Abe writes. His role as a producer has helped shape the sound of many rising talents. The Pharmacy became a hub where creativity flourished. Where all the magic happens. Its impact is still felt today, serving as a key incubator for Seattle’s emerging hip-hop voices.
You can’t forget about Ishmael Butler when talking about the Seattle scene. Also known as “Butterfly,” Abe writes that he is another former Garfield Student. Butler gained recognition on the East Coast as a member of Digable Planets, a group known for its innovative jazz-infused rap style. His approach to incorporating samples into his music became a defining trait of Seattle’s production landscape, influencing numerous artists who sought to blend diverse sounds into their work. His presence reinforced the city’s reputation as a place where creative experimentation was not only encouraged but celebrated.
The 1990s also saw the rise of Central Intelligence, a hip-hop group formed in 1997. What started as a casual project among friends evolved into something much bigger. Their music, deeply rooted in personal experiences and social consciousness, resonated with listeners who sought authenticity in their hiphop. Though the group is no longer as active, founding member Kym Wiliams has continued his journey in the industry as a producer. He carries forward the spirit of the Seattle hip-hop movement.
Reflecting on the group’s origins, Williams says, “I want to say it started off with Diopolis and I in his basement freestyling, just messing around, and he basically said to me ‘we should do a group.’ And then I thought you can’t be serious, that doesn’t sound like something we could remotely do. By 1998 there were five of us and we decided we were going to give it a shot, just kind of mess around and see what we could do with it.” This humble beginning mirrors the origins of many hip-hop groups, where passion and camaraderie fuel creativity and ambition.
Seattle’s hip-hop scene has long been a dynamic and influential force, even if it hasn’t always been in the spotlight. The city has produced pioneering artists, innovative producers and trailblazing record labels. Seattle’s hip-hop legacy is one that deserves recognition. As the genre continues to evolve, the foundation laid by these trailblazers will ensure that Seattle’s place in hip-hop history remains undeniable.




































































































































The strum of guitar sends a shock wave of adrenaline through your body. A powerful voice rocks your ears. All around you, a crowd bounces up and down, each enthusiast












same energy that







exploding with the that has you tapping your foot, clapping your hands and cheering with all you can muster. The flow of jams, the roar of all
excitement all around you, it feels completely electric. You promise




You scene of just first opportunity and musician in the internet age.



yourself that you’ll never forget how it felt to see your first live performance by an up-and-comer. It could come as a surprise to some that Ellensburg comes rife with a scene of local musical artists, many of which are just hitting their first stride. PULSE had the opportunity to sit down with some of these musicians and listen as they spun tales of how they got started, what their music means to them, their creative process and how it feels to be a musician







photos by

photos contributed by Manta, by Brenden Fuller

“I love music. Music has keep friends. Because oldest and most consistent companions. According to Kealoha, their draw to music was very natural,























been one of the most constant things in my life” says Lily Kealoha, music education major. When they were growing up, Kealoha spent a lot of time moving from place to place, making it di cult to of this, they consider music one of their












citing their Hawaiian heritage as a big inspiration for engaging with the art form. “...I have a very big family and a lot of my family members play or sing,” Kealoha says. “It was a way for me to connect and keep with my family in a way that I hadn’t been able to before.” at was how it started for them. Now, Kealoha is sharing their passion for music with the world, having




























































started recording songs to post online in 2023. ough their work is now in the public eye, open to interpretation and scrutiny, Kealoha isn’t put o by these things. “It’s been a really interesting experience,” says Kealoha on the subject of receiving feedback. “Overall, very positive.” ey go on to add that most online spaces have been welcoming of smaller creators in their experience and they’ve even received constructive criticism so that they can continue to improve. “I’m very open to listening to [criticism] because, hey, if you hear something that I can’t and then I go, you’re right, then that’s something that I can improve on” Kealoha says. Occasionally though, especially online, they encounter those whose criticism is aimed towards tearing them down rather than helping build them up. Despite that, Kealoha is undeterred, paying those types no mind and moving on.
























self-expression. “...Usually it’s a way for me to just get my feelings out instead of bottling them up,” says Kealoha. ough they don’t consider there to be a central message to any of their songs, but listeners take anything away, they want it to be that we all struggle s ometimes and that there is no shame in that. “We are all going through shit and I feel like talking about it’s very important, but also being honest with your emotions is very important,” Kealoha says. “I feel like my expression through music is me admitting mostly that I’m doing these things and it’s not a good thing. I shouldn’t be doing this, but I am because that’s being human.” True to that idea is “Back Roads”, a song that Kealoha wrote towards the end of their relationship with their last partner, particularly when they could “feel the relationship was dying.” e song expresses emotions that have resonated with several others according to Kealoha. “I get a lot of good responses whenever I perform it live and whenever I post a video about it,” says Kealoha. “And it’s just a very fun song for me to sing.”












But what makes music so important in Kealoha’s life that they’re so determined to keep creating? e answer is simple;



When it comes to encouraging new musicians, Kealoha’s advice is simply to get started. “If you’re thinking about it, just start doing it. Even if it’s not the greatest thing ever. It’s not going to be,” Kealoha says. “ e rst songs that you write, you’re going to look back on and go ‘God, how the hell did I think that sounded good at all?’ But the more that you do it, the better you’re going to do.” Another piece of advice they shared was to take inspiration from other musicians, sharing that they feel it makes one’s music better and can even elevate the material you were inspired by. When it comes to improving your music, Kealoha feels that one of the best ways it can be done is to expand your taste and horizons. “I feel like the best way to improve is to get out of your comfort zone,” says Kealoha. “Listen to artists that you normally wouldn’t listen to. Listen to your friend’s recommendations. Try and nd things that you can love in everything
that you do.”



aimed towards tearing them down rath- ways it can be done is to expand your



































































Gus Crane and Dylan Alm, co-founders of the band Manta, have known each other and been jamming together since middle school. However, their musical journeys started in di erent places. “I started playing instruments in sixth grade,” says Crane. “ I came down to [my] basement and there was a bass guitar and a banjo. I thought the bass guitar made me look cooler than the banjo. So pretty much ever since then I’ve been playing.”



performed several songs. But, what motivates them to create? For Crane and Alm, it’s a celebration of self-expression.













“It’s more about self expression, almost [in] like a performance art sense,” says Crane. “I have a lot of pent up stu that needs to get out.” But beyond simply expressing themselves, Crane and Alm want to encourage others to do the same with their own projects. On the topic of what they hope listeners will take away from their songs, Crane says “that it’s okay to be loud and it’s okay to have these kinds of inner feelings, but it’s healthier to put them out in a way that is nonviolent.” Alm echoes those same sentiments, but adds some of his thoughts on what else he wants people to take away from Manta’s songs. “I think just being yourself,” says Alm. “[Having] con dence to be yourself and to stick to your vision. And like if you have a creative idea, put it out there. [ ere’s] no point in not putting it out.”}Manta aims to express these ideas through their style of genre
almost sense,” up beyond Crane others projects. hope songs, loud inner them Alm but what else Manta’s yourself,” con to creative no in aims through of

blending, combining di erent elements of punk, alternative rock and metal. However, the two of them also feel that each of their songs sound di erent from one another and have identities of their own. However, there are some “challenges that come with being in a band and creating music. According to Crane, chief among these challenges is writer’s block. “Sometimes we get in and neither of us really have ideas or like just one of us has ideas and the other one doesn’t,” Crane says. Another challenge that they face o en is timing, which Crane admits is probably the biggest struggle for any band, which Alm readily agrees. “For any band, I think scheduling is the hardest thing. Just getting there, nding the time, the right time to [perform.]”
blending, combining di erent elements of punk, alternative rock and metal. However, the two of them also feel that each of their songs sound di erent from one another and have identities of their own. However, there are some “challenges that come with being in a band and creating music. According to Crane, chief among these challenges is writer’s block. “Sometimes we get in and neither of us really have ideas or like just one of us has ideas and the other one doesn’t,” Crane says. Another challenge that they face o en is timing, which Crane admits is probably the biggest struggle for any band, which Alm readily agrees. “For any band, I think scheduling is the hardest thing. Just getting there, nding the time, the right time to [perform.]”





















Crane cites the COVID pandemic as when he began writing music and experimenting with di erent guitars. Alm on the other hand got his start with music a year or two later than his bandmate. “I was gi ed my rst guitar when I was 14, I think,” Alm says. His uncle is a luthier, someone that makes guitars, which is where the instrument came from. “Just having that piece of equipment [boosted] me forward into trying to really make something with it instead of just learning cover songs and stu like that.” Once the pair of them were in high school, they became more serious about starting a band and o cially formed Manta once they’d graduated, deciding thatthey’d ri ed enough to start making songs together. Since then, Manta has produced and













































































































Manta also performs live at di erent venues, most notably at “Old Skool’s.” However, despite playing in a band together, Crane and Alm have di erent levels of experience when it comes to live performance. “It has been a bit of a learning curve for sure,” says Alm on the subject of his getting into live performance more recently. “But each time we do it, I think we get tighter on the songs and more in sync.” Crane on the other hand has been in other bands before, so performing live is something he has more experience with than his bandmate. “It was very nerve wracking at rst, but it became so rewarding to just get it out there and somewhat vainly, [to] have people coming up to you and complimenting you on it and telling you that you’re making cool stu ,” Crane says. Alm adds that even despite the nerves that can come with it, peforing for an audience is one of the most rewarding experiences that he’s ever had and gets to continue having show a er show.
Manta also performs live at di erent venues, most notably at “Old Skool’s.” However, despite playing in a band together, Crane and Alm have di erent levels of experience when it comes to live performance. “It has been a bit of a learning curve for sure,” says Alm on the subject of his getting into live performance more recently. “But each time we do it, I think we get tighter on the songs and more in sync.” Crane on the other hand has been in other bands before, so performing live is something he has more experience with than his bandmate. “It was very nerve wracking at rst, but it became so rewarding to just get it out there and somewhat vainly, [to] have people coming up to you and complimenting you on it and telling you that you’re making cool stu ,” Crane says. Alm adds that even despite the nerves that can come with it, peforing for an audience is one of the most rewarding experiences that he’s ever had and gets to continue having show a er show.


















































































































































































































































































































































Check out











story by Catherine Bell

photos by Keaton Weyers design by Jade Cupples
Having a bit of the winter blues? Could your pet be as well? Wondering how you can help your animals when you must leave them at home? PULSE sat down with a few pet owners and got some tips and tricks that could make your pet less blue.
Talking with Ingrid Barajas about her dog Kiko, she explains that the time spend away from Kiko is usually a 9-5 business day, with some visits in between. Barajas explains she has a tight routine with Kiko and he knows exactly what’s going on. “I want to say it’s the best part of his day, those three walks that we have,” says Barajas. They go on long walks multiple times a day as a way to get Kiko out of the house and tire him out while she’s at school or work.
The Smith family has other approaches to keeping their pets happy and healthy. PULSE talked to Phoenix and Jennifer Smith about the routines of all of their exotic pets, and what a usual day is like for them.
Discussing the possibilities of what their animals might get up too while they are gone for the six hours during the
week days. The smiths predict that the dogs Huck and Uno sleep, while the cat Coraline runs around Phoenix’s room looking at the world through his window or is outside hunting. Now the bearded dragon Gordita is usually in the same position she was when Aspen Smith comes home from school.
“Georgia gets out all the time” the Smiths proclaim that one of their dogs likes to get out and go for strolls on his own. He’ll greet them at the driveway when they come home from school. “Uno, a few times has broken out of his crate magically.” So while they seem to not have as strict of a routine as Barajas, their animals seem pretty happy.
PULSE sat down with a student Naomi Klockars, who has an emotional support animal (ESA), and Klockers told us how she feels about having her cat Mustard with her in her dorm, and how it is beneficial for both her and him.
Klockers expresses how long Mustard is alone per day. “I would say like once per day, like two hour gap. Luckily I have someone I know that checks in on him. So he’s not left alone too long.”
When Mustard is by himself for a long period of time Klockers has some special routines to keep him calm while she’s gone, “He likes to watch cartoons.” She specified, “He likes adventure time.” Wondering how to reward your cat without giving them all sorts of treats that are unhealthy, find things they like to do. Klockers expresses this by how she rewards Mustard, “He likes going outside, so I’ll take him on a leash and I’ll take him outside.”
Wondering if your mental health would increase with an (ESA), “When I was younger I had a lot of anxiety, but definitely having a cat around [helps],” says Klockers.














A fog machine starts to whir, the lights dim and flicker, dread starts to creep over you as the essence of a vampire invades your mind… or is it truly the parasite of something that has taken over society since time began? “Dracula, A Feminist Revenge Fantasy, Really” directed by Kathryn Stahl is an adaptation of Bram Stoker’s classic novel. The production was scripted by Kate Hamill in 2020 for theater through the
perspective of the character Mina Harker. Central Washington University’s Theater and Film program produced “Dracula, A Feminist Revenge Fantasy, Really” during winter 2025. PULSE had the opportunity to go behind the scenes to understand the production process of the play and take a bite into what the actors had to say about the making of their show.





























I think the biggest part in Dracula is looking at how toxic masculinity is an infection, and do you choose to use your voice or do you suffocate and through your silence become complacent to the systems of oppression?
-Kathryn Stahl | Director of ‘Dracula, A feminist



The time we find ourselves in with election, and everything going on in the world, it is important to share this story to
people in time of crisis.
Brenda Hernandez-Poblete
Mina Harker | they/she










In a basement, light filters through the windows. Two little girls perform a play for their audience. They sing, dance and act on a makeshift stage for family members who happily watch.
One of the young girls is Emily Rollie. Today, Rollie is an assistant professor in the Department of Theatre and Film at CWU, as well as a freelance director and intimacy choreographer.
Rollie has always had a love and passion for theatre. She grew up in an area of northern Minnesota that hugged the border of Canada, just a quick boat ride away. It was a small town, but it provided a lot of sources for creative outlets. “I could do music and I could do theatre and I could do speech and I could do yearbook and I could do all the things, which was awesome,” Rollie says.
Throughout Rollie’s childhood, theatre was a constant in her life,
from elementary school to middle school, high school and eventually college. “It [has] always been a part of what I do,” Rollie says, adding that the theatre gene has always been “baked into” her.
After getting her Bachelors degree in English and Education at St. Olaf’s College, Rollie found herself living in Washington where she got her masters in theatre production at Central Washington University. Rollie eventually went on to graduate school to get her PhD in Philosophy and Theatre at the University of Missouri.
Rollie studied directors for her dissertation, to delve into how fellow directors hold space for all creatives in a room. In a class setting, Rollie frequently quotes Anne Bogart and the importance of having a space for others to create art together. “Everyone having a voice in the room is important,” she says.
Rollie went on to direct numerous successful plays across the country, working in as many as 11 different states. One of the plays, “Everybody” by Branden Jacobs Jenkins, that was directed at CWU, went to National KCA and CTF and won national awards of a brave rehearsal space.
That award-winning play is “one of the things I’m most proud of,” Rollie says. “There’s a whole bunch of things, but the rehearsal space and this idea of being citizen artists whose work has power in the world.”
From a little Minnesotan dancing with stars in her eyes to today, Rollie now lectures in acting, directing and women’s studies at CWU. One of her main focuses while teaching is how important community and consent-based tools are when it comes to collaboration.







